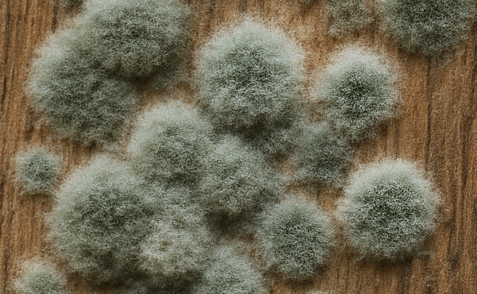

Dřevo je na stavbě skvělý materiál – lehké, pevné a obnovitelné. Zároveň je ale „živé“ a bez správné ochrany ho dříve nebo později začnou napadat plísně, dřevokazné houby a hmyz. Výsledkem jsou trhliny, měknutí a ztráta únosnosti konstrukce. Dobrou zprávou je, že většině problémů jde předejít kombinací promyšleného návrhu stavby a kvalitní impregnace.
Co dřevo nejčastěji ohrožuje
Plísně
Plísně se objevují jako skvrny nebo povlaky na povrchu dřeva. Jsou signálem dlouhodobé vlhkosti a špatného větrání. Samy o sobě většinou dřevo hned neničí, ale vytvářejí ideální podmínky pro vznik vážnějších škod.
Dřevokazné houby

Například dřevomorka domácí napadá dřevo zevnitř. Trám může vypadat v pořádku, ale postupně ztrácí pevnost. Sanace napadeného krovu je časově i finančně velmi náročná.
Dřevokazný hmyz

Tesařík krovový, červotoč a další druhy vrtají do dřeva chodbičky a oslabují průřezy nosných prvků. U krovů a stropních trámů už nejde jen o estetiku, ale o bezpečnost celé konstrukce.
Základní pravidlo: dřevo musí být co nejsušší
Nejdůležitější ochrana je vždy konstrukční. Správně navržené detaily dokážou dřevu výrazně prodloužit životnost:
- dostatečný sklon a odvodnění střechy,
- odvětrané skladby krovů, podbití a dřevěných fasád,
- vyhnout se místům, kde voda může dlouhodobě stát,
- neukončovat prvky „na plocho“ tam, kde do nich může zatékat.
Teprve na druhém místě přichází chemická ochrana, která funguje jako pojistka tam, kde nejsou podmínky ideální.
Jak funguje chemická ochrana dřeva
Moderní impregnační prostředky obsahují fungicidy (proti houbám a plísním) a insekticidy (proti hmyzu). Aplikují se nátěrem, postřikem nebo máčením. Nejde o krycí barvu, ale o roztok, který se vsakuje do dřeva a chrání ho zevnitř.
Typickým zástupcem této skupiny je koncentrovaný přípravek TYTAN PROFESSIONAL W1 PROFI. Je vodou ředitelný, určený pro dlouhodobou preventivní ochranu stavebního dřeva v interiéru i exteriéru a působí proti plísním, dřevokaznému hmyzu i houbám. Vhodný je pro dřevo v třídách použití 1, 2 a 3 dle ČSN EN 335 (interiér, krytý exteriér, exteriér vystavený povětrnosti).
Kde má impregnace největší smysl
Střešní konstrukce a krovy
Krov je často skrytý v izolaci a není snadno přístupný. Jakýkoli problém se odhalí až ve chvíli, kdy je pozdě. Proto je vhodné impregnovat veškeré dřevo použitím máčení nebo alespoň dvou nátěrů před montáží.
Pergoly, terasy, ploty a zahradní stavby
Tyto prvky jsou vystaveny dešti, slunci i mrazu. Samotná lazura nebo barva dřevo před biologickým napadením neochrání. Ideální je spojení: nejprve impregnace (například W1 PROFI) a teprve poté dekorativní lazura nebo lak.
Vnitřní pohledové prvky
Pohledové trámy, obklady nebo podhledy bývají v méně větraných prostorách. Zde se osvědčuje bezbarvá impregnace, která nezmění vzhled dřeva, a následně tenkovrstvá lazura nebo olej.
Správný postup ošetření krok za krokem
- Příprava podkladu
Dřevo musí být suché, čisté, bez kůry, prachu a zbytků starých nátěrů. Na mokrý nebo promrzlý podklad impregnační prostředek nepatří. - Ředění a množství
U koncentrovaných přípravků je nutné dodržet doporučené ředění i minimální spotřebu na m². Například pro nátěr v interiéru se běžně používá ředění 1 : 9 (koncentrát : voda), v exteriéru se volí stejný poměr, ale s vyšší spotřebou na m². - Způsob aplikace
Pro menší stavby stačí nátěr nebo postřik. Pro větší série prvků je ideální máčení, které zajistí rovnoměrný příjem přípravku. - Čas na fixaci
Po aplikaci je třeba nechat dřevo v klidu, aby se účinné látky ve struktuře dřeva zafixovaly. Během této doby by dřevo nemělo zmoknout ani být omýváno. - Vrchní dekorativní nátěr
V exteriéru je téměř nutností – chrání proti UV záření a snižuje praskání povrchu. Vybírejte lazury a laky, které jsou s impregnačním prostředkem kompatibilní.
Jak dlouho ochrana vydrží
Při dodržení technologického postupu může být ochrana v interiéru prakticky neomezená – stačí pravidelné vizuální kontroly. V exteriéru se u kvalitních systémů počítá minimálně s desetiletou životností a následnou periodickou kontrolou stavu nátěrů.
Časté chyby, kterým se vyhnout
- spolehnout se pouze na lazuru nebo barvu bez impregnace,
- aplikovat prostředek na mokré či promrzlé dřevo,
- ředit „od oka“ a nanést příliš slabý nátěr,
- použít biocid na dřevo v kontaktu s potravinami nebo pitnou vodou, kde to výrobce výslovně nedovoluje.
Shrnutí
Ochrana dřeva proti plísním, dřevokaznému hmyzu a houbám není jen otázka jednoho nátěru navíc. Jde o kombinaci správného konstrukčního řešení a kvalitního impregnačního prostředku. Pokud dřevo ošetříte už před montáží a budete respektovat doporučenou technologii, výrazně snížíte riziko nákladných oprav krovu, pergoly nebo dřevěné fasády v budoucnu.
